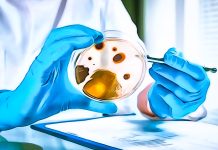
microbiological criteria EU analyses

Disinformation about the authenticity of honey marketed in Europe returns mainstream and affects even the readers of a serious newspaper like The Guardian in the UK, unfortunately.
It theorises that 9 out of 10 jars of honey in the UK would have failed ‘authenticity tests’, but fails to report the complete lack of probative value of the testing method used. (1) A closer look.
1) Honey authenticity, 10 years of false alarms
RASFF – the European Rapid Alert System on Food and Feed – has only recorded 30 notifications of non-conformity of honey, royal jelly and propolis on the EU market and at its borders over the past 25 years. The reports mainly concerned residues of pesticides or non-approved veterinary medicines, on honey of European and non-European origin.
The false alarms in Europe on the authenticity of non-European honey – and in particular that coming from China, the world’s leading producer – have been repeated for a decade now, as we have already observed. (2) And the agricultural sector of the Old Continent has also been able to influence the European institutions to impose a climate of suspicion that, as we shall see, is without foundation.
1.1) European Commission, coordinated actions
The first plan of controls on the authenticity of honey in the EU – coordinated by the European Commission (2015-2017), with the support of its JRC (Joint Research Centre) – had suspected non-compliance in 14.2% of the cases analysed. Based on:
– sampling of a total of 2,264 European and non-European honey samples in 30 European countries (EU-28, Norway, Switzerland)
– use of a single method of analysis (EA/LC-IRMS) whose reliability has recently been confirmed in European standardisation (see paragraph 2.1 below).
The second plan of controls coordinated by Brussels in 2021-2022, on the other hand, ended with a report that 47% of honey imported into the EU from non-EU countries was not authentic. A false alarm, as it turned out, since it was based on:
– a very small sampling. 320 samples (half of those planned) of non-EU honey only, taken over a few months in 17 countries using non-harmonised methods;
– analyses carried out by the authorities of the various European countries using different analysis methods, in official laboratories that are sometimes not even accredited, (3) with results that often lack scientific and legal value
– ‘suspicions’ of non-compliance hypothesised through experimental interpretation of the results, by JRC, of five different methods of analysis. (4)
1.2) EU Honey Directive reform (2024)
The reform of the EU Honey Directive 2001/110/EC, carried out through the Breakfast Directive (EU) No 2024/1438, in turn:
– asserts, without any scientific basis, the existence of a ‘close link between the quality of honey and its origin‘ (whereas 3);
– calls the European Commission’s coordinated action ‘From the Hives’ (2023) to point out that ‘a high percentage of honey placed on the Union market is suspected of being adulterated‘ (whereas 7);
– introduces, on these unfounded premises, a honey origin labelling scheme unprecedented in European law. It prescribes the indication, on the front of the label, of the countries of origin of the honeys used and the exact percentages of honeys of different origins included in their blends (5,6).
2) Honey authenticity, sampling and analysis methods
Official Controls Regulation (EU) No 2017/625, as seen above, requires official control authorities and designated official laboratories at national and European level, respectively, to follow:
– the methods of sampling and analysis defined in European legislation. Or, in their absence
– methods in accordance with relevant internationally recognised standards or protocols, including those accepted by the European Committee for Standardisation (CEN). Or, where these are not available
– relevant methods developed or recommended by EU reference laboratories and validated according to internationally accepted scientific protocols. And only in the absence
of the above-mentioned standards or protocols
– methods in accordance with relevant nationally defined standards or, if no such standards exist, relevant methods developed or recommended by EU reference laboratories and validated according to internationally accepted scientific protocols. Or, as a last resort
– relevant methods developed and validated by interlaboratory or intralaboratory studies on the validation of methods according to internationally accepted scientific protocols (OCR, Article 34.2).
Respect for the hierarchy of methods of analysis, the so-called ‘cascade principle’, is the conditio-sine-qua-non for attributing legal (as well as scientific) value to their results. (7)
2.1) CEN, LC-IRMS method
CEN (European Committee for Standardisation) adopted on 24 June 2024 the standard EN 17958:2024: Food authenticity – Determination of the 013C value of mono- (fructose and glucose), di-, and trisaccharides in honey by liquid chromatography-isotope ratio mass spectrometry (LC-IRMS).
The new standard – due to be published on 27 November 2024 – ‘specifies a method for the determination of the stable carbon isotope ratio (13C/12C) of sugars in honey using liquid chromatography coupled to an isotope ratio mass spectrometer (LC-IRMS) for the separation of compounds and subsequent determination of the 13C/12C ratio of mono-, di-, and trisaccharides.
These ratios can be used to assess the authenticity of honey by comparing them with the guide values of authentic honey, previously agreed upon by experts in the field, since the 13C/12C ratios of sugars in authentic honey and sugars in adulterants (syrups obtained from starch-rich plants or from sugar cane or sugar beet) differ to a certain extent‘.
The LC-IRMS method of analysis is therefore now the only standardised method that can be used, in official controls and other official activities of the competent authorities, to ascertain the authenticity of honey with respect to possible adulterations with sugars from C3 plants (e.g. beet). In addition to the AOAC 998.12 standard method already in use for checking adulterations with sugars from C4 plants (e.g. maize).
2.2) Other ‘authenticity tests’ of honey
Other ‘authenticity tests’ for honey – such as the DNA analysis propagated by the Celvia laboratory in Estonia, the results of which have been the subject of misleading press reports, in the UK as well as in Germany (1) – are completely devoid of legal (as well as scientific) value, in the light of the criteria mentioned above (Official Controls Regulation, Article 34).
Moreover, the European legislator has delegated the European Commission to establish, by 14 June 2028, the methods of analysis to verify the authenticity of honey. Taking into account both international standards – such as standard EN 17958:2024 – and technical progress, which must, however, follow appropriate paths of scientific validation (see section 3.2 below).
3) Mainstream misinformation
The Guardian reports that ‘9 out of 10 honey samples bought in UK supermarkets have failed the authenticity test‘. (1) The article’s sensationalist title is misleading in itself, for several reasons:
– the sampling appears to have been carried out on 25 jars of honey bought ‘from large retailers, including supermarkets‘, and 5 jars of honey produced by UK beekeepers, without giving any details about this;
– author of the sampling would be the UK branch of an international organisation, ‘The Honey Authenticity Network’. This organisation states apodictically on the homepage of its website that ‘one third of the honey traded internationally is adulterated or 100% fake‘; (8)
– the Honey Authenticity Network allegedly commissioned an ‘authenticity test’ from a private laboratory, Celvia in Estonia, which ‘developed its new methodology for DNA testing of honey with the support of the EU’s European Agricultural Fund for Rural Development’; (9)
– the news about the supposed ‘non-authenticity’ of the tests is therefore based on an experimental method of analysis, not even considered in the latest JRC publication on the subject, (10) the results of which have no legal value. And of very doubtful scientific value, as will be seen.
3.1) ‘Authenticity test’, DNA analysis, honey database
The laboratory Celvia in Estonia, according to The Guardian, bases its ‘authenticity test’ of honey on a DNA comparison with ‘a database of over 500 genuine honeys, about half of which come from Estonia‘.
Celvia’s database therefore contains:
– over 250 honey DNA matrices from a microscopic country like Estonia (45 km2)
– less than 250 matrices hypothetically representing a territory 333 thousand times larger, if only the top 5 countries from which honey imported into the EU originates are considered. (11)
3.2) Validation of analysis methods
The validation of methods of analysis also requires their appropriate verification, which includes comparisons with other methods and ring tests (i.e. application of the same method in different laboratories). To ascertain the requirements of:
– accuracy (trueness and precision); applicability; limits of detection and quantification; precision; repeatability; reproducibility; recovery; selectivity; sensitivity; linearity; uncertainty of measurements; any other criteria of choice. (12)
4) Provisional conclusions
The denigrating campaign against honeys produced anywhere in the world unfairly damages the image of a natural food that better than others expresses the values of health, biodiversity and respect for the environment. (13) To the benefit of other foods (e.g. sugar, high fructose syrups) and artificial sweeteners, which are not as virtuous.
Throwing petrol on the fire is all the more inappropriate now that the European Commission has set up the EU Honey Platform with the primary objectives of:
– gathering data for methods to improve authenticity controls of honey, with a view to possibly harmonising them;
– providing recommendations with a view to establishing a Union reference laboratory.
Dario Dongo
Notes
(1) Jon Ungoed-Thomas. Nine in ten honey samples from UK retailers fail authenticity test. The Guardian. November 9, 2024 https://tinyurl.com/4byzc47a
(2) Dario Dongo. Chinese counterfeit honey, fake news. FT (Food Times). December 5, 2018
(3) See section 1.3 (Accreditations) in the previous article by Dario Dongo, Maria Ada Marzano. FT (Food Times). Microbiological criteria, analysis methods in EU. October 10, 2024
(4) Dario Dongo. Non-EU Import Honey, The European Commission’s Ambiguous Report. GHO (Global Honey Organization). July 15, 2024
(5) Directive (EU) 2024/1438 of the European Parliament and of the Council of 14 May 2024 amending Council Directives 2001/110/EC relating to honey, (…) https://tinyurl.com/ms7a8e4w
(6) Dario Dongo. Breakfast Directives, The European Parliament Raises The Barriers Against Non-EU Honey. GHO (Global Honey Organization). April 18, 2024
(7) Dario Dongo. Official controls and analysis methods in the EU, the ‘cascade principle’. FT (Food Times). October 20, 2024
(8) The Honey Authenticity Network https://www.honeyap.org
(9) Authentic honey meets DNA technology. The EU CAP Network https://tinyurl.com/j6hadwmk
(10) Ždiniaková, T., Loerchner, C., De Rudder, O., Dimitrova, T., Kaklamanos, G., Breidbach, A., Respaldiza Hidalgo, M.A., Vaz Silva, I.M., Paiano, V., Ulberth, F. and Maquet, A. EU Coordinated action to deter certain fraudulent practices in the honey sector (EUR 31461 EN). Publications Office of the European Union, Luxembourg, 2023. doi:10.2760/184511
(11) Non-EU honey imported into Europe in 2023, according to Eurostat (https://tinyurl.com/4sabzux5), comes mainly from:
– China (60,200 tonnes, 37% of total honey imports)
– Ukraine (45,800 tonnes, 28%)
– Argentina (20,400 tonnes, 12%)
– Mexico (10,700 tonnes, 7%)
– Cuba (4,700 tonnes, 3%).
The total area of the above-mentioned countries, which also differ from Estonia in terms of geography and climate, is approximately 15 million m2 . That is, approximately 333,333 times the area of Estonia
(12) Official Controls Regulation (EU) No 2017/625, Article 34.4 and Annex II
(13) Dario Dongo, Srikanth Vuppala. Honey, biodiversity and economy in low- and middle-income countries. FT (Food Times). July 4, 2024
Dario Dongo, lawyer and journalist, PhD in international food law, founder of WIISE (FARE - GIFT - Food Times) and Égalité.